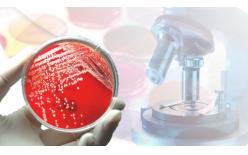

您當前的位置:首頁 > 鋁/銅異種金屬材料

架空絞線產品——鋁包鋼絞線、鋁包鋼芯鋁絞線、鋁包鋼芯成型鋁絞線、鋁包鋼芯鋁合金絞線、鋁包鋼芯成型鋁合金絞線 鋁包鋼絞線的檢測項目 組成絞線的各類單線根數 組成絞線的各類單線尺寸 外徑 絞向 絞合節徑比 線密度 表面情況(狀況) ...查看詳情>>

架空絞線產品——鋁包鋼絞線、鋁包鋼芯鋁絞線、鋁包鋼芯成型鋁絞線、鋁包鋼芯鋁合金絞線、鋁包鋼芯成型鋁合金絞線
鋁包鋼絞線的檢測項目
組成絞線的各類單線根數
組成絞線的各類單線尺寸
外徑
絞向
絞合節徑比
線密度
表面情況(狀況)
應力-應變曲線
導線拉斷力
蠕變
單線抗拉強度
單線1﹪伸長時的應力
單線斷裂伸長率
單線20℃時直流電阻率
單線卷繞
單線扭轉
鋁包鋼線鋁層厚度
電線電纜產品標準檢測標準
一、架空絞線
1)架空絞線產品標準
1.GB/T 1179-2017 圓線同心絞架空導線
2.GB/T 20141-2006 型線同心絞架空導線
2)架空絞線檢測標準
1.GB/T 3048-2007 電線電纜電性能試驗方法
2.GB/T 3428-2012 架空絞線用鍍鋅鋼線
3.GB/T 4909-2009 裸電線試驗方法
4.GB/T 17048-2017 架空絞線用硬鋁線
5.GB/T 17937-2009 電工用鋁包鋼線
6.GB/T 23308-2009 架空絞線用鋁-鎂-硅合金圓線
二、塑料絕緣控制電纜
1)塑料絕緣控制電纜產品標準
1.GB/T 9330.1-2008 塑料絕緣控制電纜 第1部分:一般規定
2.GB/T 9330.2-2008 塑料絕緣控制電纜 第2部分:聚氯乙烯絕緣和護套控制電纜
3.GB/T 9330.3-2008 塑料絕緣控制電纜 第3部分:交聯聚乙烯絕緣控制電纜
2)塑料絕緣控制電纜產品標準
1.GB/T 2951-2008 電纜和光纜絕緣和護套材料通用試驗方法
2.GB/T 3048-2007 電線電纜電性能試驗方法
3.GB/T 3956-2008 電纜的導體
4.GB/T 19666-2005 阻燃和耐火電線電纜通則
三、擠包絕緣低壓電力電纜
1)擠包絕緣低壓電力電纜產品標準
1.GB/T 12706.1-2008 額定電壓1kV(Um=1.2kV)到35kV(Um=40.5kV)擠包絕緣電力電纜及附件 第1部分:額定電壓1kV(Um=1.2kV)和3kV(Um=3.6kV)電纜
2.GB/T 31840.1-2015 額定電壓1kV(Um=1.2kV)到35kV(Um=40.5kV)鋁合金芯擠包絕緣電力電纜 第1部分: 額定電壓1kV(Um=1.2kV)和3kV(Um=3.6kV)電纜
3.GB/T 19666-2005 阻燃和耐火電線電纜通則
2)擠包絕緣低壓電力電纜產品標準
1.GB/T 2951-2008 電纜和光纜絕緣和護套材料通用試驗方法
2.GB/T 3048-2007 電線電纜電性能試驗方法
3.GB/T 3956-2008 電纜的導體
4.GB/T 11091-2014 電纜用銅帶
5.GB/T 16927.1-2011 高電壓試驗技術 第1部分:一般定義及試驗要求
6.YB/T 024-2008 鎧裝電纜用鋼帶
四、擠包絕緣中壓電力電纜
1)擠包絕緣中壓電力電纜產品標準
1.GB/T 12706.2-2008 額定電壓1kV(Um=1.2kV)到35kV(Um=40.5kV)擠包絕緣電力電纜及附件 第2部分:額定電壓6kV(Um=7.2kV)到30kV(Um=36kV)電纜
2.GB/T 12706.3-2008 額定電壓1kV(Um=1.2kV)到35kV(Um=40.5kV)擠包絕緣電力電纜及附件 第3部分:額定電壓35kV(Um=40.5kV)電纜
3.GB/T 31840.2-2015 額定電壓1kV(Um=1.2kV)到35kV(Um=40.5kV)鋁合金芯擠包絕緣電力電纜 第2部分:額定電壓6kV (Um=7.2kV)到30kV(Um=36kV)電纜
4.GB/T 31840.3-2015 額定電壓1kV(Um=1.2kV)到35kV(Um=40.5kV)鋁合金芯擠包絕緣電力電纜 第3部分:額定電壓35kV(Um=40.5kV)電纜
5.GB/T 19666-2005 阻燃和耐火電線電纜通則
2)擠包絕緣中壓電力電纜檢測標準
1.GB/T 2951-2008 電纜和光纜絕緣和護套材料通用試驗方法
2.GB/T 3048-2007 電線電纜電性能試驗方法
3.GB/T 3956-2008 電纜的導體
4.GB/T 11091-2014 電纜用銅帶
5.GB/T 16927.1-2011 高電壓試驗技術 第1部分:一般定義及試驗要求
6.YB/T 024-2008 鎧裝電纜用鋼帶
五、架空絕緣電纜
1)架空絕緣電纜產品標準
1.GB/T 12527-2008 額定電壓1kV及以下架空絕緣電纜
2.GB/T 14049-2008 額定電壓10kV架空絕緣電纜
2)架空絕緣電纜產品標準
1.GB/T 2951-2008 電纜和光纜絕緣和護套材料通用試驗方法
2.GB/T 3048-2007 電線電纜電性能試驗方法
3.GB/T 3953-2009 電工圓銅線
4.GB/T 3955-2009 電工圓鋁線
5.GB/T 4909-2009 裸電線試驗方法
6.GB/T 17048-2017 架空絞線用硬鋁線
7.GB/T 23308-2009 架空絞線用鋁-鎂-硅合金圓線
收起百科↑ 最近更新:2018年11月28日

隨著科學技術和工業生產的迅速發展,人們對機械零部件的質量要求也越來越高。材料質量和零部件的精密度雖然得到很大的提高,但各行業中使用的機械零部件的早期失效仍時有發生。通過失效分析,找出失效原因,提...
檢測機構:深圳市美信檢測技術股份有限公司 更多相關信息>>

隨著現代工業的發展,人類對重金屬的開發冶煉和制造加工活動日益增多,導致環境污染嚴重。而環境中的重金屬通過水體、蔬菜、水果、魚、禽肉等多種途徑嚴重威脅了人類的健康。中安檢測可以為客戶提供全面的重金屬和微...
檢測機構:四川省中安檢測有限公司 更多相關信息>>

主要檢測項目 不銹鋼10%草酸浸蝕試驗 不銹鋼硫酸-硫酸鐵腐蝕試驗 不銹鋼65%硝酸腐蝕試驗 不銹鋼硝酸-氫氟酸腐蝕試驗 不銹鋼硫酸...
檢測機構:青島蘇試海測檢測技術有限公司 更多相關信息>>

翎鈞實驗室可為客戶提供未知物成分分析、高分子材料成分分析服務: 塑料高分子主成分檢測、成分鑒定; 填料、配料、玻纖含量分析; 整體配方分析; 粒子...
檢測機構:上海翎鈞檢測技術有限公司 更多相關信息>>

現實生活中,各種金屬件因為受到自然界的腐蝕都會發生生銹等的現象,我司擁有很多進口或者國產的鹽霧箱,能夠模擬自然界進行加速腐蝕測試,同時擁有經驗豐富的工程師,能夠為您的產品提供相關的建議和幫助。 ...
微生物會引起食品的腐敗和變質,而病原微生物更是人類健康的可怕殺手,世界各國對食品中的微生物均有嚴格的管控。 CTI提供多種微生物測試服務,以降低產品由微生物所帶來的風險。 ...
檢測機構:深圳市華測檢測技術股份有限公司 更多相關信息>>

鹽霧試驗是一種利用鹽霧試驗設備所創造的人工模擬鹽霧環境條件來確認產品或金屬材料耐腐蝕性能的環境試驗。試驗的嚴苛程度取決于曝露持續時間。 實驗室模擬鹽霧可以分為三類:中性鹽霧試驗、醋酸...
檢測機構:深圳一通檢測技術有限公司 更多相關信息>>